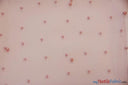
Very Soft Tulle with Pearls | Tulle with Beads | 52" Wide | Bridal Veil Tulle, Wedding Dress | Fabric mytextilefabric Yards Blush Pink

Very Soft Tulle with Pearls | Tulle with Beads | 52" Wide | Bridal Veil Tulle, Wedding Dress |
- Tulle with Beads is as simple as it sounds - tone on tone beads matching with tulle.
- Fabric by the Yard is sold with a min of 2 yards - a quantity of 10 means 10 yards.
- You may also request a Sample Swatch.
Very Soft Tulle with Pearls | Tulle with Beads | 52" Wide | Bridal Veil Tulle, Wedding Dress | - is backordered and will ship as soon as it is back in stock.
Very Soft Tulle with Pearls | Tulle with Beads | 52" Wide | Bridal Veil Tulle, Wedding Dress | - is backordered and will ship as soon as it is back in stock.
Description
Description
Cleaning Instructions
Fabric is Dry Clean Only. Do not wash and or machine wash this item.
Picture Taken
Picture is taken with and/or without flash depending on the color. If you are very particular about the color tone - please order a sample swatch to avoid any issues.
Fabric Weight
Approximately 3 oz per linear yard. Very soft hand feel with light body weight.
Fabric Width
52" Wide
Quality/Origin
Color Waves
Color Waves
We have a Strict no Return Policy on our orders - If you are very particular with a color - please order a sample swatch to make sure the color is correct.
Dye Lot Variations
Dye Lot Variations
Dye lots may vary from order to order - As fabric rolls finish - we open new rolls and dye lots may vary from time to time - please order a sample swatch to assure the current dye lot you will be receiving
Full Piece and/or Splits
Full Piece and/or Splits
We strive to give one full piece cut orders. At times our rolls end and or full pcs are not available and splits may occur. Some fabric rolls come straight from our mill unpackaged and untouched but will have a few splits in the rolls. We do not guarantee one full pieces - if this is an issue - please contact our reps prior to purchasing
Payment & Security
Payment methods
Your payment information is processed securely. We do not store credit card details nor have access to your credit card information.